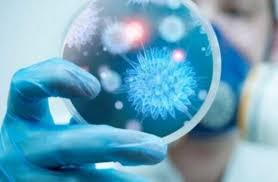

اكتشفت السلطات الصحية في الصين اربع اصابات جديدة بالالتهاب الرئوي بعد تفشي ما يعتقد أنها سلالة جديدة من فيروس كورونا بمدينة ووهان في وسط البلاد، بحسب "الغد برس".
وأكدت لجنة الصحة في ووهان في بيان لها اليوم السبت، إنه "تم تشخيص الأفراد الأربعة بالالتهاب الرئوي يوم الخميس الماضي، وإن حالتهم مستقرة".
يشار الى ان حالات الاصابة تقتصر على أفراد سافروا أو عاشوا في ووهان،حيث أصيب حوالي 50 شخصا حتى الآن بالعدوى.
من جانبها حذرت منظمة الصحة العالمية المستشفيات في مختلف أنحاء العالم من احتمال اتساع نطاق التفشي ، لذا تسعى منظمة الصحة العالمية والصين ودول أخرى إلى الحيلولة دون انتشار الفيروس قبل عطلة رأس السنة القمرية الجديدة الأسبوع المقبل، حيث ينشط سكان الصين خلال هذه الفترة والبالغ عددهم 1.4 مليار بالسفر إلى خارج البلاد.
سوسن البياتي.. Zagros tv

التعليقات (0)
لا توجد تعليقات حتى الآن